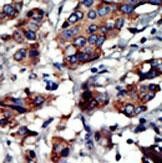

PACSIN3 Antibody (N-term)
Purified Rabbit Polyclonal Antibody (Pab)
- SPECIFICATION
- CITATIONS
- PROTOCOLS
- BACKGROUND

Application
| IHC-P, WB, E |
|---|---|
| Primary Accession | Q9UKS6 |
| Reactivity | Human, Mouse |
| Host | Rabbit |
| Clonality | Polyclonal |
| Isotype | Rabbit IgG |
| Calculated MW | 48487 Da |
| Antigen Region | 1-30 aa |
| Gene ID | 29763 |
|---|---|
| Other Names | Protein kinase C and casein kinase substrate in neurons protein 3, SH3 domain-containing protein 6511, PACSIN3 |
| Target/Specificity | This PACSIN3 antibody is generated from rabbits immunized with a KLH conjugated synthetic peptide between 1-30 amino acids from the N-terminal region of human PACSIN3. |
| Dilution | IHC-P~~1:50~100 WB~~1:2000 E~~Use at an assay dependent concentration. |
| Format | Purified polyclonal antibody supplied in PBS with 0.09% (W/V) sodium azide. This antibody is purified through a protein A column, followed by peptide affinity purification. |
| Storage | Maintain refrigerated at 2-8°C for up to 2 weeks. For long term storage store at -20°C in small aliquots to prevent freeze-thaw cycles. |
| Precautions | PACSIN3 Antibody (N-term) is for research use only and not for use in diagnostic or therapeutic procedures. |
| Name | PACSIN3 |
|---|---|
| Function | Plays a role in endocytosis and regulates internalization of plasma membrane proteins. Overexpression impairs internalization of SLC2A1/GLUT1 and TRPV4 and increases the levels of SLC2A1/GLUT1 and TRPV4 at the cell membrane. Inhibits the TRPV4 calcium channel activity (By similarity). |
| Cellular Location | Cytoplasm. Cell membrane; Peripheral membrane protein; Cytoplasmic side. Note=Detected at the inner aspect of the plasma membrane in myotubes. |
| Tissue Location | Widely expressed, with highest levels in heart and skeletal muscle, intermediate levels in placenta, liver and pancreas, and very low levels in brain, lung and kidney |

Thousands of laboratories across the world have published research that depended on the performance of antibodies from Abcepta to advance their research. Check out links to articles that cite our products in major peer-reviewed journals, organized by research category.
info@abcepta.com, and receive a free "I Love Antibodies" mug.
Provided below are standard protocols that you may find useful for product applications.
Background
Protein kinases are enzymes that transfer a phosphate group from a phosphate donor, generally the g phosphate of ATP, onto an acceptor amino acid in a substrate protein. By this basic mechanism, protein kinases mediate most of the signal transduction in eukaryotic cells, regulating cellular metabolism, transcription, cell cycle progression, cytoskeletal rearrangement and cell movement, apoptosis, and differentiation. With more than 500 gene products, the protein kinase family is one of the largest families of proteins in eukaryotes. The family has been classified in 8 major groups based on sequence comparison of their tyrosine (PTK) or serine/threonine (STK) kinase catalytic domains. The STE group (homologs of yeast Sterile 7, 11, 20 kinases) consists of 50 kinases related to the mitogen-activated protein kinase (MAPK) cascade families (Ste7/MAP2K, Ste11/MAP3K, and Ste20/MAP4K). MAP kinase cascades, consisting of a MAPK and one or more upstream regulatory kinases (MAPKKs) have been best characterized in the yeast pheromone response pathway. Pheromones bind to Ste cell surface receptors and activate yeast MAPK pathway.
References
Howard, L., et al., J. Biol. Chem. 274(44):31693-31699 (1999). Modregger, J., et al., J. Cell. Sci. 113 Pt 24, 4511-4521 (2000). Sumoy, L., et al., Gene 262 (1-2), 199-205 (2001).
If you have used an Abcepta product and would like to share how it has performed, please click on the "Submit Review" button and provide the requested information. Our staff will examine and post your review and contact you if needed.
If you have any additional inquiries please email technical services at tech@abcepta.com.





Foundational characteristics of cancer include proliferation, angiogenesis, migration, evasion of apoptosis, and cellular immortality. Find key markers for these cellular processes and antibodies to detect them.
The SUMOplot™ Analysis Program predicts and scores sumoylation sites in your protein. SUMOylation is a post-translational modification involved in various cellular processes, such as nuclear-cytosolic transport, transcriptional regulation, apoptosis, protein stability, response to stress, and progression through the cell cycle.
The Autophagy Receptor Motif Plotter predicts and scores autophagy receptor binding sites in your protein. Identifying proteins connected to this pathway is critical to understanding the role of autophagy in physiological as well as pathological processes such as development, differentiation, neurodegenerative diseases, stress, infection, and cancer.